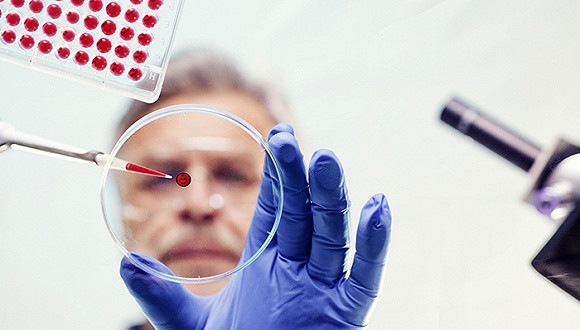

Win10無緣政府采購 蘋果將推出三款新iPad
發表日期:2016.08.16 訪問人數:789
Win10無緣政府采購 微軟中國合資公司或將難產
“2015年�����,中國智能終端操作系統產業聯盟委托一些權威測評機構就Win8和Win10的相似度進行了測評�����,證明Win8與Win10內核基本一致”,中國工程院院士倪光南說�����,“政府采購部門將Win10與Win8同等對待��,不列入政府采購目錄���,也沒有另行發布通知��。”
2016年8月15日,多位中國工程院院士聯合數位網絡安全專家在北京舉辦座談會。本次會議上�,中國工程院院士倪光南發表署名文章《中國發展關鍵核心技術的指導方針》����,文章首次對外公布了2013年12月20日《在中國工程院一份建議上的批示》(簡稱“1220批示”)�����。
以操作系統為主題的座談會,不可避免會在部分主題中涉及到占據中國97%市場的Windows操作系統。“這些年來���,中國人為Windows花費的錢以千億元計。但這么大的市場、這么多的錢并沒有換來或買到什么Windows的核心技術”���,倪光南引用《在網絡安全和信息化工作座談會上的講話》解讀道:“市場換不來核心技術,有錢也買不來核心技術,必須靠自己研發、自己發展�����。”
唯品會第二季度凈利6800萬美元 同比增長13.1%
8月16日�����,唯品會(紐交所證券代碼:VIPS)今天發布了該公司截至6月30日的2016財年第二季度未經審計的財報���。
財報顯示�����,唯品會第二季度總凈營收為134.4億元人民幣(約合20.2億美元),比去年同期增長49%�;歸屬于唯品會普通股股東的凈利潤為4.516億元人民幣(約合6800萬美元)�,比去年同期增長13.1%�。
唯品會今年第二季度總凈營收為20.2億美元,高于業界分析師平均預計的19億美元���;經調整的每股攤薄利潤為0.17美元,高于業界分析師平均預計的0.15美元。與此同時��,TheStreet Ratings分析師還將唯品會股票評級定為“買入”級���。
諾基亞手機可能真的要回來了
據外媒報道�,芬蘭公司HMD Global Oy正計劃重新推出諾基亞品牌的手機。該公司周一宣布,已聘請《憤怒的小鳥》開發商Rovio前CEO佩卡·蘭塔拉(Pekka Rantala)為首席營銷官����。
諾基亞今年5月宣布,與HMD簽訂排他性授權協議��,將諾基亞品牌手機重新推向市場�����。
作為諾基亞的資深員工�,蘭塔拉于1994年至2011年一直供職于該公司��。他于2015年加入Rovio擔任CEO��,但在1年后就宣布離職�����。Rovio也進行了大幅裁員和重組。
蘋果明年將推出三款新的iPad 包括10.5英寸的iPad Pro
外媒引述知名蘋果分析師郭明池的話說�����,明年蘋果可能會推出一款10.5英寸的iPad Pro���,以及一款低價版9.7英寸的平板��。
這位分析師表示���,預計在2017年�����,蘋果將會推出三款新的iPad,包括12.9英寸的iPad Pro 2�����,全新尺寸的10.5英寸iPad Pro�,以及低價版的9.7英寸平板�。
他表示,由于行業性的市場變化�,因此蘋果產品線的調整�����,不太可能換來平板電腦銷量的增長,預計2017財年蘋果平板電腦發貨量�,將會同比萎縮10%到20%��。
這位分析師還表示,預計兩款iPad Pro將會采用A10X應用處理器�,這一處理器由臺積電獨家代工制造����,采用10納米工藝�。而低成本的9.7英寸平板,將會采用A9X處理器�,該處理器也可能由臺積電獨家制造����。